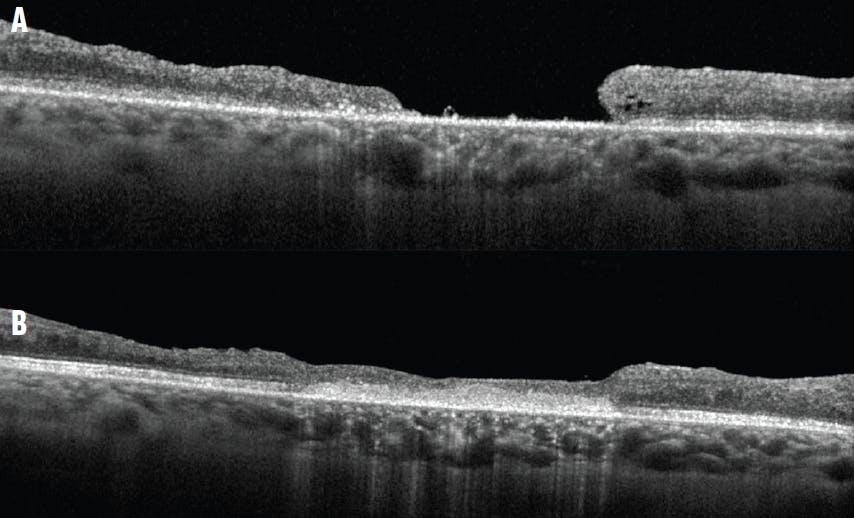
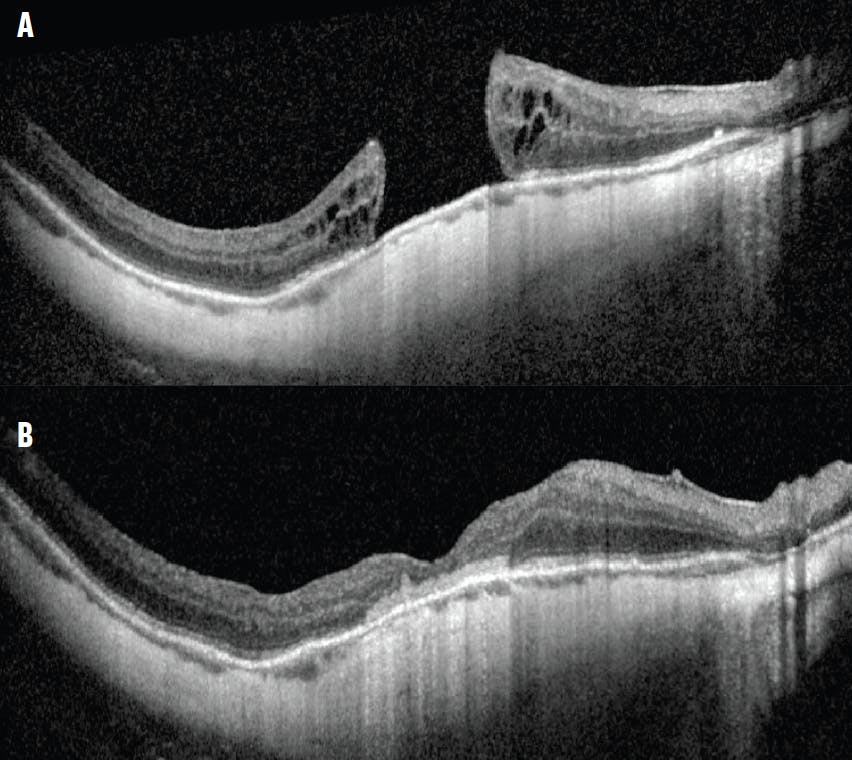

AT A GLANCE
- In complex macular hole cases, surgeons often need to employ advanced techniques or a combination of advanced maneuvers.
- Preoperative OCT imaging can help guide surgical decision making.
- Hydrodissection, lysis of retina–retinal pigment epithelium adhesions, flexible nitinol loop massage, and amniotic membrane placement can be employed to close complex macular holes.
Modern vitreoretinal surgical techniques, such as pars plana vitrectomy (PPV) with gas tamponade with or without internal limiting membrane (ILM) peeling, have resulted in high single-operation success rates for macular hole (MH) closure. However, refractory idiopathic MHs and complex secondary MHs (ie, those that are complicated by coexisting pathology such as proliferative vitreoretinopathy [PVR], tractional retinal detachment [RD], pathologic myopia, or macular telangiectasia type 2) remain a challenge. A more advanced technique or a combination of various advanced maneuvers is often required to manage these atypical scenarios.
Two cases illustrate how a combination of maneuvers—such as hydrodissection, lysis of retina–retinal pigment epithelium (RPE) adhesions, flexible nitinol loop (eg, Finesse Flex Loop [Alcon]) massage, and placement of an amniotic membrane (AM) graft—can help to close complex MHs.1-3
REAL-WORLD EXAMPLES
Case No. 1: A woman in her 30s with type 1 diabetes and severe nonproliferative diabetic retinopathy who developed vitreomacular traction and an epiretinal membrane (ERM) underwent PPV with ERM and ILM peeling and gas tamponade. After surgery, she developed a large full-thickness MH for which she underwent a second PPV with additional ILM peeling and gas tamponade. The MH failed to close, and she was referred to us for a second opinion (Figure 1A). At initial presentation to our clinic, her VA was counting fingers. We performed MH hydrodissection, MH massage, subretinal AM placement, and SF6 gas. Her VA improved to 20/100 approximately 9 months postoperatively (Figure 1B).
Figure 1. Preoperative OCT imaging shows a large MH measuring approximately 1,300 µm with a flat-open configuration (A). OCT imaging obtained 9 months after PPV, MH hydrodissection, MH massage, subretinal AM placement, and SF6 gas shows closure of the hole (B).
Case No. 2: A man in his 30s with high myopia (axial length approximately 30 mm) and a history of a giant retinal tear-associated RD experienced multiple recurrent RDs secondary to PVR and subsequent MH formation. The MH persisted despite a prior PPV with ERM and ILM peeling. The patient was referred to us for a second opinion and presented with a MH measuring approximately 1,250 µm at the narrowest inner aperture (Figure 2A). His preoperative VA was counting fingers.
He underwent PPV, peeling of residual vitreoschisis, ERM and ILM peeling, subretinal AM placement, and C3F8 gas tamponade (Figure 2B).
Figure 2. Preoperative OCT imaging shows a large MH measuring approximately 1,250 µm (A). Postoperative OCT imaging shows MH closure after PPV, peeling of the residual vitreoschisis, peeling of the ERM and ILM, subretinal AM placement, and C3F8 gas (B).
PREOPERATIVE OCT GUIDES SURGICAL MANAGEMENT
In cases of refractory MHs, preoperative OCT can facilitate the detection of a residual ERM and the assessment of the configuration and size of the MH (especially the narrowest inner retinal aperture). Preoperative OCT can also aid in the identification of other possible causes of poor visual potential such as a thin or absent retinal nerve fiber layer that may suggest optic neuropathy.
Preoperative OCT imaging for the patient in the first case showed a large irregular MH measuring approximately 1,300 µm at the narrowest inner diameter. Importantly, the hole had a flat-open configuration, as opposed to the anvil configuration typically seen with acute idiopathic MHs in which the MH edges (often with cystic changes) are slightly elevated by a cuff of subretinal fluid. Th flat-open configuration may indicate the presence of retina–RPE adhesions and may alert the surgeon that, for the edges to mobilize, hydrodissection or blunt dissection may be helpful. The same may be necessary for an AM to be easily positioned subretinally and anchored under the MH’s edges. In the first case, lysis of the adhesions was required before an AM could be introduced into the subretinal space.
In contrast, the MH in the second case had an anvil configuration with slight elevation and cystic changes of the edges. In general, this configuration suggests that there may not be significant adhesions at the MH edges. In this case, an AM was easily inserted under the edges without the necessity of first lysing adhesions.
ADDITIONAL PEELING
It is generally helpful to restain the macular surface with brilliant blue or indocyanine green dyes (with or without triamcinolone acetonide) and check for the presence of residual vitreoschisis, ERM, and ILM. It is not unusual to encounter these, even if the prior operative report states that the ILM was peeled. Anecdotally, this appears to be more likely in patients with high myopia (especially vitreoschisis) or those with a blonde fundus because the ILM stain is more difficult to appreciate. If additional membranes are encountered, they should be peeled to the greatest extent possible (eg, from the superotemporal to the inferotemporal vascular arcade).4,5 It is also possible to harvest residual ILM for an inverted, rotational, or free ILM flap to cover the MH and serve as a scaffold for closure.
ADDRESSING ADHESIONS
As discussed above, retina–RPE adhesions at the MH edges may limit mobilization of these edges for successful closure. In these cases, it may be helpful to perform MH hydrodissection. This technique can be performed in a variety of ways, including refluxing fluid (balanced salt solution) via a backflush or soft tip directly through the MH, creating subretinal fluid blebs that extend to the hole with a subretinal cannula,6,7 or using a soft-tipped cannula to reflux fluid transretinally in an area of peeled ILM.8 Another method of lysing retina–RPE adhesions is to use a blunt delamination spatula or even a lighted pick. These instruments can be inserted under the MH edges and used to lift and separate the retina–RPE adhesions. These techniques come with the risk of trauma to the outer retina and the RPE and must be performed with care.
Another method of mobilizing the retina is to massage the edges of the hole with a flexible nitinol loop. In many instances, the MH diameter visibly decreases intraoperatively with this maneuver. However, this technique also carries the risk of damage to the inner retina if not performed carefully.
AMNIOTIC MEMBRANE
We prefer to use a cryopreserved AM (AmnioGraft, BioTissue), but the use of a dehydrated AM is another option.9 The membrane can be cut to the appropriate size with a circular biopsy punch or scissors.
Staining the surface of the AM with brilliant blue dye can make it easier to identify the basement membrane surface. The AM is then peeled from the carrier paper using forceps and introduced into the vitreous cavity through 23- or 25-gauge cannulas. If the surgeon loses the orientation of the membrane in the vitreous cavity and cannot identify the basement membrane side from the stromal side, brilliant blue dye can help. Moreover, the stromal side is stickier and will be more adherent to the forceps. In some situations, the use of a bimanual technique with chandelier illumination can allow the use of two instruments to help manipulate the AM.
The goal is to place the stromal side against the exposed RPE inside the MH. With forceps or a blunt delamination spatula, the AM is pushed underneath the edges of the hole. The membrane should lie as flat as possible; otherwise, it may bunch up in the center of the MH postoperatively and block apposition of the edges, as opposed to lying as a flat disk over which the retinal layers can reapproximate. Surgery concludes with whichever tamponade the surgeon prefers, including short-acting agents such as air or SF6.10
ALTERNATIVES
Numerous alternative techniques exist for addressing refractory or complex MHs. This article highlights only a few of the adjunctive techniques that may be useful with subretinal AM placement, but they should not be used in every case; careful consideration should be given to other techniques such as autologous retinal transplantation.11 While further research may suggest that this technique may yield better visual acuity results, it is technically more challenging, typically requires more than one surgery (for removal of the PFO liquid or silicone oil), and may carry a greater risk of complications. In our experience, many patients with refractory MHs are wary of additional surgery and are thus drawn to AM placement.
1. Rizzo S, Caporossi T, Tartaro R, et al. A human amniotic membrane plug to promote retinal breaks repair and recurrent macular hole closure. Retina. 2019;39(suppl 1):S95-S103.
2. Caporossi T, Pacini B, Bacherini D, Barca F, Faraldi F, Rizzo S. Human amniotic membrane plug to promote failed macular hole closure. Sci Rep. 2020;10(1):18264.
3. Bamberger MD, Felfeli T, Politis M, Mandelcorn ED, Galic IJ, Chen JC. Human amniotic membrane plug for chronic or persistent macular holes. Ophthalmol Retina. 2022;6(5):431-433.
4. Ch’ng SW, Patton N, Ahmed M, et al. The Manchester Large Macular Hole Study: Is it time to reclassify large macular holes? Am J Ophthalmol. 2018;195:36-42.
5. Baumann C, El-Faouri M, Ivanova T, et al. Manchester Revisional Macular Hole Study: predictive value of optical coherence tomography parameters on outcomes of repeat vitrectomy, extension of internal limiting membrane peel, and gas tamponade for persistent macular holes. Retina. 2021;41(5):908-914.
6. Szigiato AA, Gilani F, Walsh MK, Mandelcorn ED, Muni RH. Induction of macular detachment for the treatment of persistent or recurrent idiopathic macular holes. Retina. 2016;36(9):1694-1698.
7. Felfeli T, Mandelcorn ED. Macular hole hydrodissection: surgical technique for the treatment of persistent, chronic, and large macular holes. Retina. 2019;39(4):743-752.
8. Lee G. Transretinal subretinal fluid injection technique for refractory or chronic large macular holes. Paper presented at: ASRS 2022; July 14-16, 2022; New York, NY.
9. Huang YH, Tsai DC, Wang LC, Chen SJ. Comparison between cryopreserved and dehydrated human amniotic membrane graft in treating challenging cases with macular hole and macular hole retinal detachment. J Ophthalmol. 2020;2020:9157518.
10. Caporossi T, Tartaro R, Finocchio L, et al. Human amniotic membrane to treat macular holes that failed to close, sulfur hexafluoride endotamponade versus air endotamponade: a prospective comparative study. Retina. 2021;41(4):735-743.
11. Moysidis SN, Koulisis N, Adrean SD, et al. Autologous retinal transplantation for primary and refractory macular holes and macular hole retinal detachments: The Global Consortium. Ophthalmology. 2021;128(5):672-685.



















